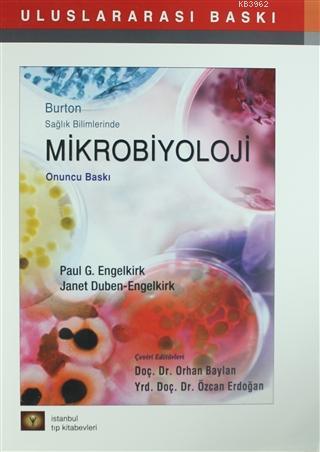
Mikrobiyoloji; Burton Sağlık Bilimlerinde

- Anasayfa
- Tıp - Sağlık
- Acil Tıp
- Adli Tıp
- Aile Hekimliği
- Alternatif Tıp
- Anatomi
- Anestezi
- Annelik ve Çocuk Bakımı
- Başvuru Sağlık Kitapları
- Beslenme - Diyet
- Beyin Cerrahi
- Biyokimya
- Biyoloji - Genetik
- Cinsellik
- Çocuk Cerrahi
- Dermatoloji
- Diş Hekimliği
- Endokrinoloji
- Farmakoloji
- Fizik Tedavi - Rehabilitasyon
- Fizyoloji
- Gastroenteroloji
- Genel Cerrahi
- Genel Sağlık Kitapları
- Gerontoloji
- Göğüs Cerrahisi
- Göğüs Hastalıkları
- Göz
- Hamilelik ve Doğum
- Hematoloji - Onkoloji
- Hemşirelik
- Histoloji ve Embriyoloji
- İç Hastalıkları
- İlaç Rehberleri
- İlk Yardım
- İmmünoloji
- Kadın Hastalıkları ve Doğum
- Kalp Damar Cerrahi
- Kardiyoloji
- Kbb
- Mikrobiyoloji - İnfeksiyon
- Nefroloji
- Nöroloji
- Nükleer Tıp
- Ortopedi
- Patoloji
- Pediatri
- Plastik Cerrahi
- Popüler Sağlık
- Psikiyatri
- Radyoloji
- Romatoloji
- Spor Hekimliği
- Şifalı Bitkiler
- Tıp Sözlükleri
- Tıp Tarihi ve Felsefesi
- Üroloji
- Veterinerlik
- Yabancı Dilde Tıp Kitapları
- Yoğun Bakım
- Tıp - Sağlık
Mikrobiyoloji - İnfeksiyon - Kategori kitapları
15